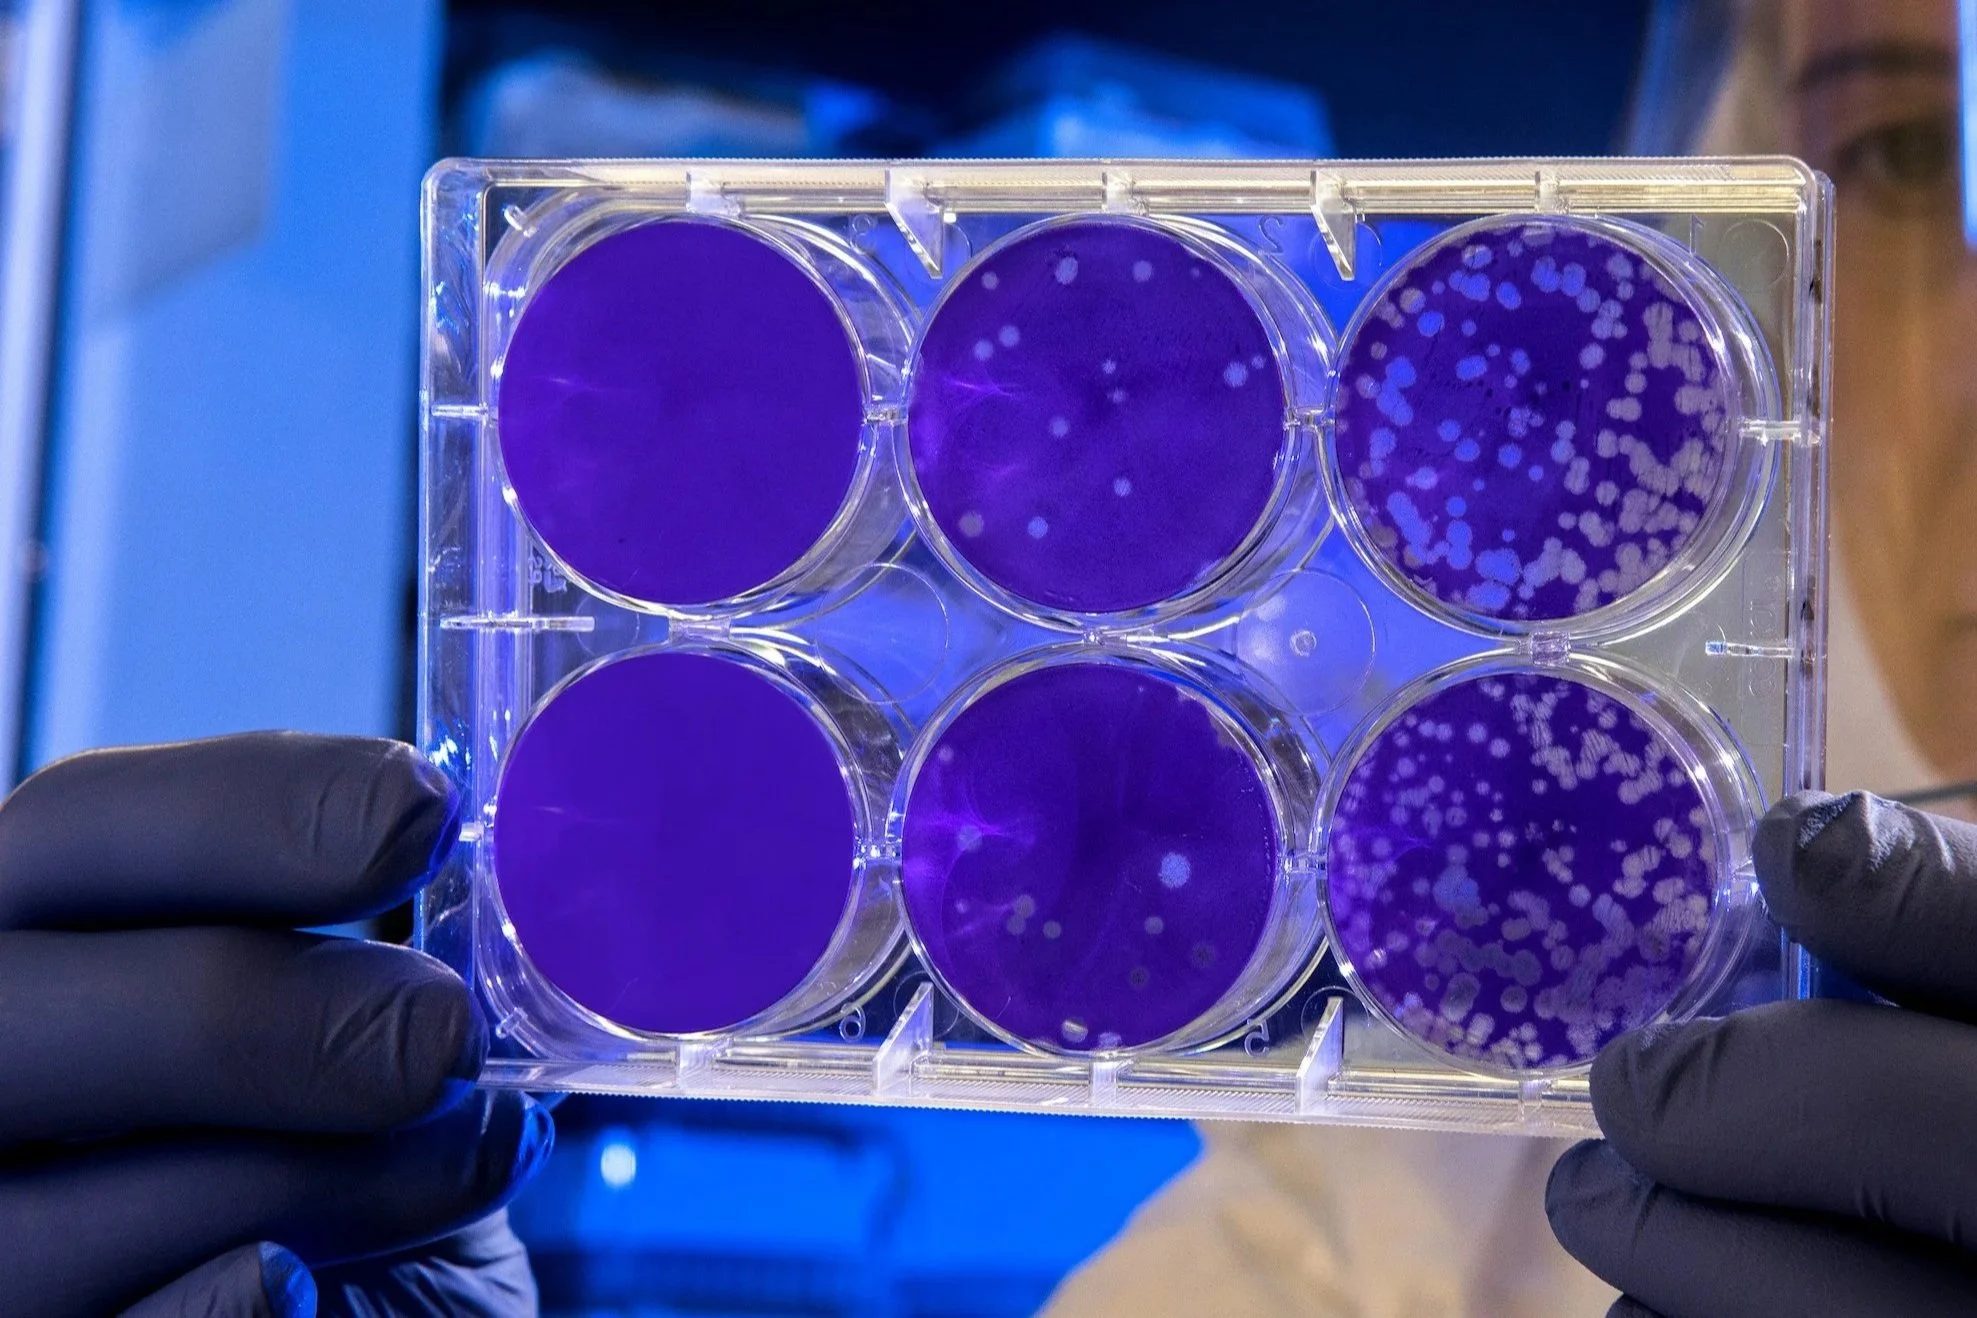

Research & education
Dr. Jarrahy leads a full-time research program housed within UCLA’s Regenerative Bioengineering and Repair (REBAR) Lab. His dedicated team conducts both basic science and clinical research, with findings presented at numerous prestigious national and international conferences. Through innovative thinking and scientific rigor, Dr. Jarrahy has authored numerous peer-reviewed publications that have significantly contributed to the advancement of craniofacial surgery.

legacy
The research fellows trained under Dr. Jarrahy’s mentorship carry forward a legacy of academic excellence that defines our program. These individuals have gone on to secure prestigious positions for their clinical training and are poised to become the next generation of leaders in academic plastic surgery.
Basic Science
Regenerative Medicine
Tissue Engineering
Bone Regeneration
Biomaterials
Nerve Regeneration
Stem Cell Therapies
Burn Wound Reconstruction
Adipose Derived Stem Cells
Transplantation
Research Interests

Clinical
Comparison of Cleft Lip and Palate Techniques
Outcomes in Cranioplasty
Orthognathic Surgery
Radiology in Craniofacial Surgery
Psychosocial Development in Children with Facial Deformities
